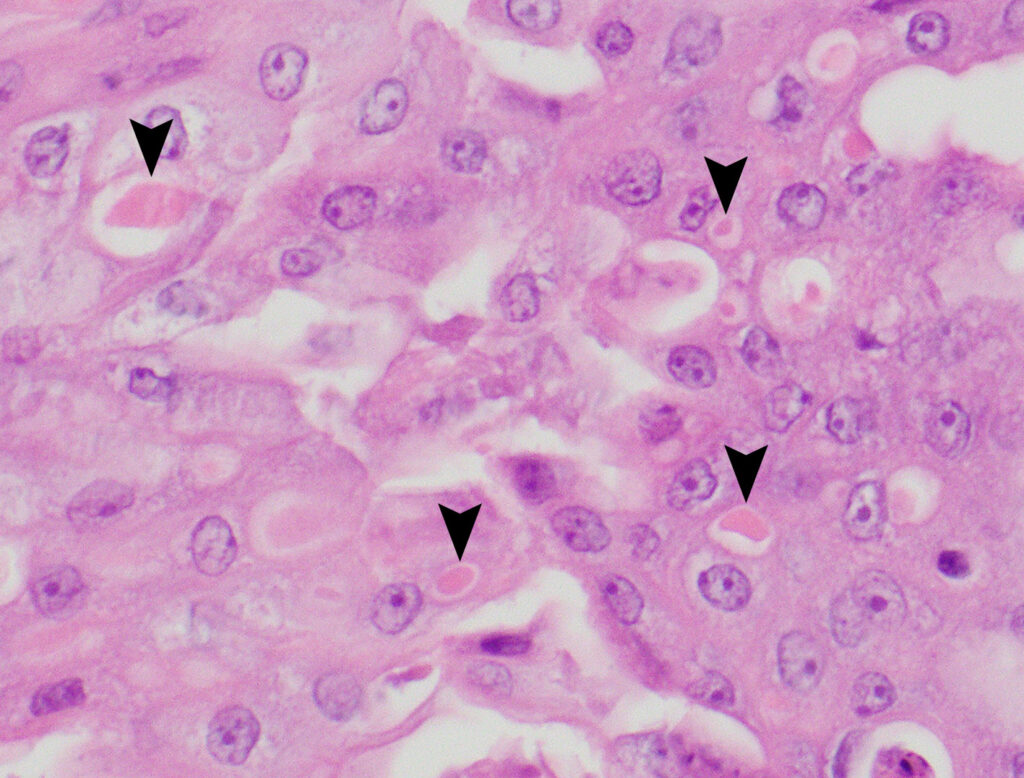
Foto: Jooske IJzer

De groenling staat dit jaar extra in de belangstelling bij het Dutch Wildlife Health Centre (DWHC), het centrum dat ziekten onder in het wild levende dieren in Nederland signaleert en onderzoekt. In het eerste kwartaal van 2016 zijn zestien meldingen van dode groenlingen en andere vinkachtigen binnengekomen. Hiervan konden twaalf vogels worden opgehaald en onderzocht. Het ging om negen groenlingen, twee sijzen en een putter.
 |
 |
 |
Doodsoorzaken
Uit het onderzoek bleek dat de twee sijzen door lichamelijk letsel (trauma) waren doodgegaan, en dat alle groenlingen door een ziekte waren gestorven. Hierbij zijn vier verschillende ziekten als doodsoorzaak gevonden. Bij zes groenlingen was Het Geel (Trichomonas-infectie) de oorzaak, waarvan in sommige gevallen echter nog sprake is van een voorlopige uitslag (verdenking). Een speciale test (PCR-test) moet deze verdenking later dit jaar al dan niet bevestigen. De andere drie ziekten die als oorzaak voor de sterfte van de groenlingen werden aangetoond, zijn: vogelpokken, Yersiniose en Salmonella-infectie. De putter bleek al te lang dood om nog te kunnen onderzoeken.
De groenlingen met Het Geel hadden een gelig ‘beslag ‘ in of een ontsteking van de krop. Vaak denken mensen bij het zien van een geel beslag of een ontsteking in de bek dat de vogel is doodgegaan door Het Geel, maar dit hoeft niet altijd het geval te zijn, omdat dit ziektebeeld ook bij andere ziekten past. Zo had ook de groenling met vogelpokken een hevige ontsteking van de krop en de groenling met Yersiniose had ook ‘beslag’ in de bek.
 |
|
Aanleiding groenling als speerpuntdier
De ziekte Het Geel, die vooral bekend is als één van de doodsoorzaken bij duiven, is enkele jaren geleden ook bij groenlingen gevonden. In Engeland wordt de sterke daling van het aantal groenlingen in verband gebracht met deze ziekte. Ook in Zweden wordt vermeld dat de populatie groenlingen sterk is gedaald na de 1e uitbraak van deze ziekte in 2008. Het DWHC wil, samen met Sovon, het Vogeltrekstation en de Universiteit Utrecht, beter zicht krijgen op het vóórkomen en de verspreiding van Het Geel onder groenlingen en andere vinkachtingen in Nederland. In Nederland lijkt de ziekte (nog) geen effect te hebben op de populatieomvang, maar ook dit aspect zal door de betrokken organisaties worden onderzocht. Daarom hebben zij begin dit jaar via verschillende media een oproep gedaan om dode groenlingen en andere vinkachtigen te melden voor onderzoek naar de doodsoorzaak.
Help mee en blijf dode groenlingen en vinken melden
Het melden van dode groenlingen en andere vinkachtingen kan via de website van DWHC of via sovon.nl/nl/dodevogels. Voor het microscopisch onderzoek is het essentieel dat de dieren ‘vers’ zijn, wat betekent dat ze maximaal één dag dood zijn en niet zijn ingevroren. Meld dode dieren daarom zo snel mogelijk. ‘Vink’ daarbij op het meldformulier van Sovon aan dat je het dier wilt insturen voor onderzoek.
Na het melden van het dier, neemt DWHC contact met u op en overleggen we of het dier wordt opgehaald. U krijgt dan een instructie over hoe het dier te verpakken. DWHC heeft geen ophaaldienst die de dode vogel uit het veld ophaalt, maar wel een koerier die het in plastic zakken verpakte dier bij de melder (of een ander adres) kan ophalen. Het is belangrijk dat het dode dier zo koel mogelijk wordt bewaard (maar niet ingevroren) tot het wordt opgehaald.
Foto banner: Dick Pasman

